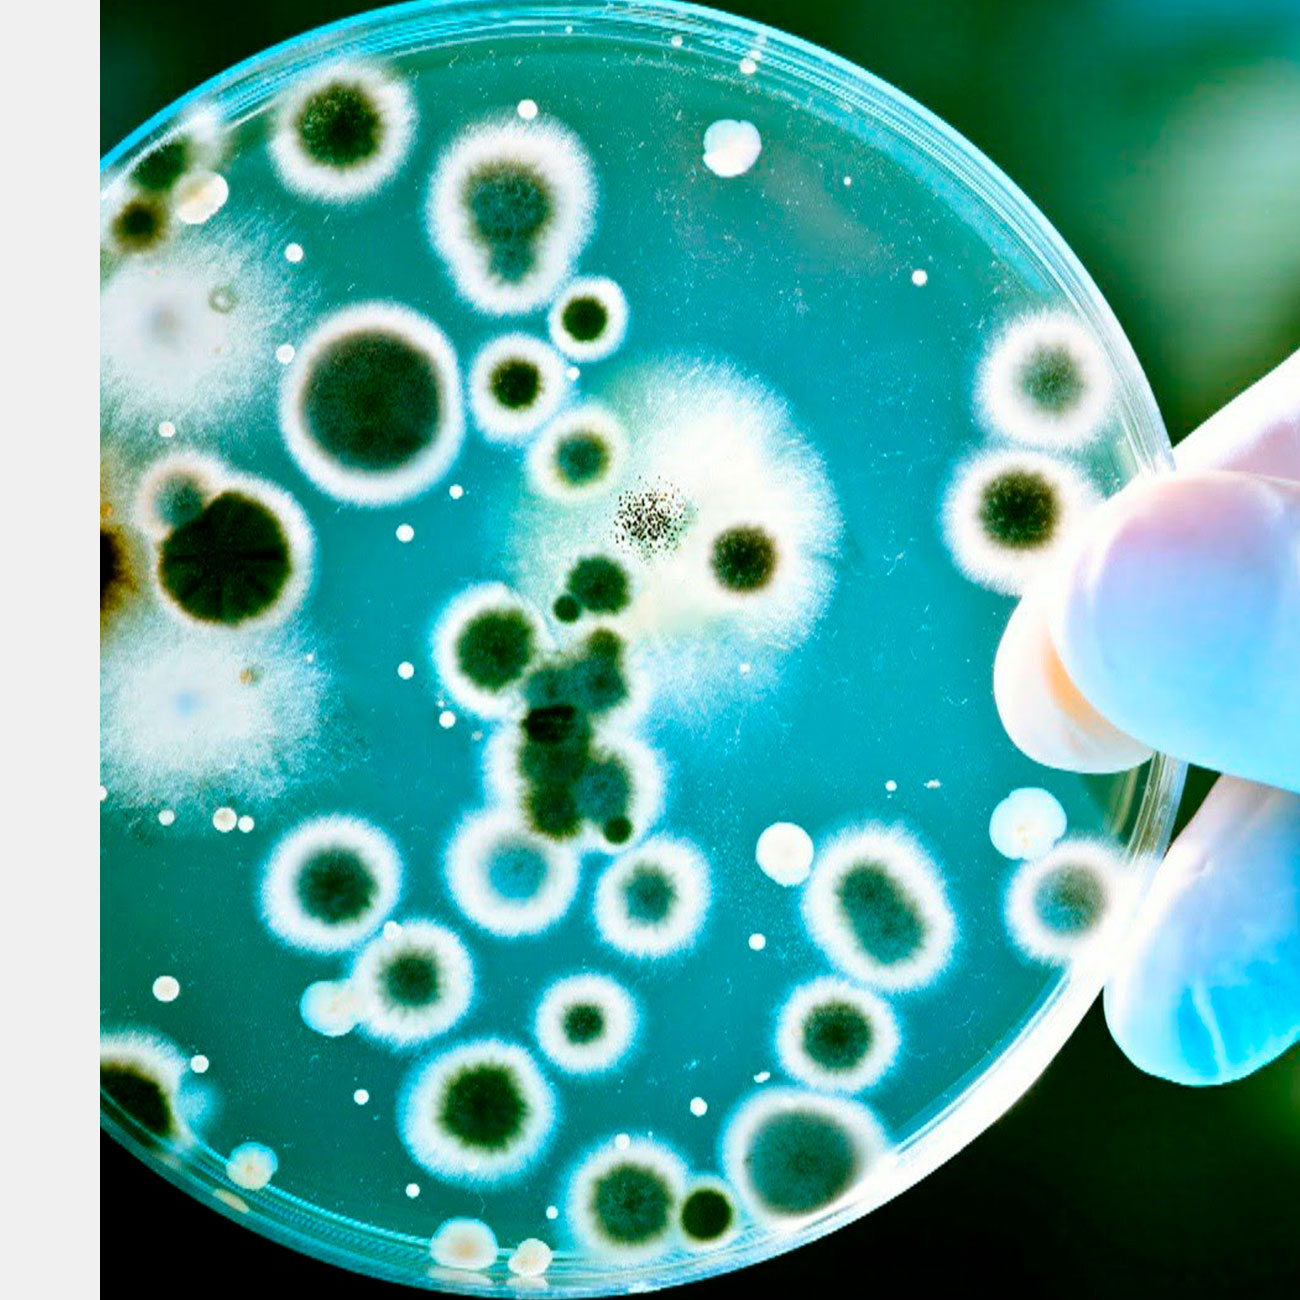

Исторические книги полны интересными фактами о жизни известных людей — о них порой известно так много, что среди этой информации можно найти даже список их любимых блюд. В то же время об обычных людях известно крайне мало, но исследователи из Бристольского университета заполнили эти пустоты. Благодаря химическому анализу керамической посуды, они впервые точно определили, чем питались средневековые простолюдины из Англии.
Группа ученых из нескольких китайских учреждений разработала гидрогель, способный остановить кровотечение из проколотой артерии, одно из сильнейших и опаснейших для человека. В своей статье, опубликованной в Nature Communications, ученые описывают, как был сделан гидрогель и насколько хорошо он работал на подопытных животных. Неконтролируемое кровотечение — очень серьезная ситуация, как во время хирургических процедур, так и полученное в результате травмы.
Видите изображение в статье? С помощью этого странного изображения нейробиологи Массачусетского технологического института смогли активировать отдельные нейроны мозга. Используя лучшую из доступных модель зрительной нейронной сети мозга, ученые разработали новый способ точного управления отдельными нейронами и их популяциями в середине этой сети. В ходе испытания на животных команда показала, что информация, полученная из вычислительной модели, позволила им создавать изображения, которые сильно активировали определенные нейроны мозга.
Ученые, по сути, получили способ обращаться к мозгу через изображение «напрямую», минуя длинный путь осмысления изображений. Но прежде чем вы задумаетесь о мрачном будущем, в котором нас действительно будут зомбировать с экранов телевизора, давайте обо всем по порядке.
С момента открытия в 1929 году антибиотиков прошло много лет, и за это время опасные бактерии научились защищаться от своих главных убийц. У них выработались защитные механизмы, и если ученые не найдут действенные способы обойти их, человечество вновь может стать уязвимым к огромному количеству болезней. У некоторых бактерий защита состоит аж из двух слоев — благо, исследователи из Университета Томаса Джефферсона нашли способ уничтожить их за один раз.
Мозг поглощает огромное количество кислорода и питательных веществ, поэтому, когда перестают работать лёгкие и сердце, мозг умирает чрезвычайно быстро. Однако уже больше ста лет исследователи стараются как-то продлить жизнь мозгу после остановки сердца – его охлаждают, через него искусственным образом прокачивают кровь или её заменитель, и т. д. Удалось также показать, что клетки мозга сохраняют некоторые признаки жизни и после смерти – например, они могут синтезировать белки, если их снабдить нужными ресурсами.
Исследователи из Йеля решили пойти дальше и попытались оживить не отдельные нейроны, но мозг в целом. Для этого у тридцати двух свежеубитых свиней вынимали мозг и подсоединяли к особой системе BrainEx, которая прокачивала через сосуды мозга специальный раствор, имитирующий кровь. От момента смерти до подключения к системе BrainEx проходило 4 часа, однако несмотря на это в течение следующих шести часов с искусственной кровью жизнь к мозгу частично вернулась.